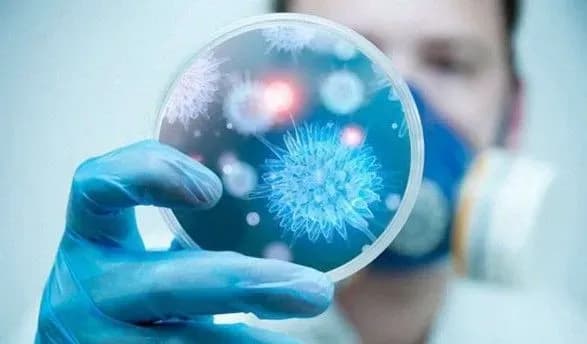
u-filippinakh-vpershe-za-19-rokiv-spalakh-poliomiyelitu

"Філіппіни у четвер оголосили про спалах поліомієліту, через 19 років після того, як Всесвітня організація охорони здоров'я оголосила країну Південно-Східної Азії вільною від інфекційного захворювання", - йдеться у повідомленні.
Міністр охорони здоров'я країни Франциско Дюк заявив, що було підтверджено "повторне виникнення поліомієліту" після одного випадку захворювання у 3-річної дівчинки в південній провінції Ланао дель Сур та ще однієї підозри захворювання зі схожою симптоматикою. У поверненні хвороби він звинувачує "погане охоплення імунізацією", антисанітарію, неналежну гігієну та поганий нагляд з боку медичних працівників.
Міністр повідомив, що уряд приступає до нової кампанії вакцинації проти поліомієліту за підтримки ВООЗ. "Ми наполегливо закликаємо батьків, медичних працівників та органів місцевого самоврядування повністю брати участь у синхронізованій вакцинації проти поліомієліту", - сказав Дюк, додавши, що вакцинація - єдиний спосіб "зупинити спалах поліомієліту та захистити свою дитину від цієї паралізуючої хвороби".
ЧИТАЙТЕ ТАКОЖ: В Україні 29% людей погоджуються, що вакцини безпечні – опитування
Поліомієліт - інфекційне захворювання, яке швидко поширюється і в основному вражає маленьких дітей. Він може викликати м’язову слабкість, параліч і, інколи, може бути смертельним. Не існує ліків від поліомієліту, але йому можна запобігти за допомогою кількох доз вакцин проти поліомієліту.
Нагадаємо, що в Україні невакцинованими лишаються понад 400 тисяч дітей.